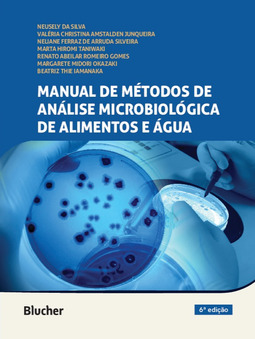

CADASTRE-SE
MANUAL DE MÉTODOS DE ANÁLISE MICROBIOLÓGICA DE ALIMENTOS E ÁGUA
Neusely Da Silva , Valeria Christina Amstalden Junqueira , Neliane Ferraz De Arruda Silveira , Marta Hiromi Taniwaki , Renato Abeilar Romeiro Gomes , Margarete Midori Okazaki , Beatriz Thie Iamanaka (0) votos | (0) comentários
Sinopse
O Manual de métodos de análise microbiológica de alimentos e água é um manual de laboratório ilustrado contendo os métodos recomendados por órgãos internacionais (APHA, FDA, USDA, AOAC, ISO) aceitos pela Agência Nacional de Vigilância Sanitária (ANVISA).
Cada capítulo traz uma revisão profunda e atualizada sobre o(s) microrganismo(s) tratado(s), incluindo posição taxonômica, mudanças na nomenclatura, características morfológicas e bioquímicas e epidemiologia. Oferece também comparações esquemáticas entre os métodos disponíveis, destacando suas diferenças e similaridades. A apresentação didática do passo a passo dos métodos em figuras esquemáticas permite uma rápida apreensão dos procedimentos, facilitando sua execução no dia a dia dos laboratórios.
| Categoria | |
| Editora | Blucher |
| ISBN-13 | 9786555062977 |
| ISBN | 6555062975 |
| Edição | 6 / 2021 |
| Idioma | Português |
| Páginas | 602 |
| Estante | 0 0 0 0 |
| Sua estante | |
6% chance de ser solicitado
CADASTRE-SE
AVALIAÇÃO DO LEITOR
Quero comentar sobre este livro